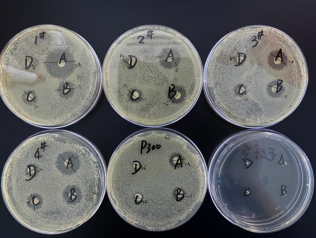
紙片法實驗圖片

一、實驗原理
利用抑菌劑不斷溶解經(jīng)瓊脂擴散形成不同濃度梯度,已顯示其抑菌作用。實驗通過抑菌圈大小判斷其是否具有抑菌能力。
二、實驗器材
100mm培養(yǎng)皿、離心管、移液器、超凈臺、計數(shù)板、生理鹽水、生化培養(yǎng)箱、無菌蒸餾水、接種環(huán)、大豆酪蛋白瓊脂培養(yǎng)基等。
菌種:
自然菌液: 吸取西寶生物實驗室水槽,衛(wèi)生間下水池,一樓下水管,以及大門口的養(yǎng)魚池的水,一共大約20ml, 進行自然沉降,取上清液部分。
防腐劑:
1.Seebio KroVin300防腐劑(共四個批次,用P1、P2、P3、P4標識)
2.某進口品牌的P**300
2.某進口品牌的P**300
三、實驗步驟
1、實驗工具準備及滅菌
2、培養(yǎng)基制備
稱取10.5g培養(yǎng)基干粉,加入300ml純化水,攪拌加熱煮沸至完全溶解。再加入6g的葡萄糖,攪拌溶解。向各培養(yǎng)皿內(nèi)注入約20ml的熔化狀瓊脂培養(yǎng)基(約45℃),待其冷卻,備用。
3、防腐劑配制
用蒸餾水對不同類防腐劑分別按照1:250、1:500、1:1000、1:2000配制 ,做好標記。
4、菌懸液制備
取適量菌種加入生理鹽水1ml,稀釋10倍,采用平板計數(shù)法,稀釋,得到10^6CFU/ml濃度菌懸液。
5、試驗菌接種
10^6CFU/ml試驗菌懸液0.2ml,將其接種到已經(jīng)倒好培養(yǎng)基的培養(yǎng)皿內(nèi),用涂布棒涂布均勻(每次使用涂布棒前酒精燈下滅菌),蓋好培養(yǎng)皿。
6、添加防腐劑
6.1 紙片法
用鑷子將圓片約5.5mm濾紙平均放置在培養(yǎng)皿上,每個培養(yǎng)皿放置4個圓濾紙(4個防腐劑濃度用)。吸取不同種類,不同濃度的防腐劑3ul,加入到圓濾紙中,讓防腐劑溶液分布滿整個濾紙,但又不溢出,蓋好培養(yǎng)皿。
6.2 打孔法
在培養(yǎng)皿里培養(yǎng)基上打4個孔,用100ul槍頭打孔。各孔中心之間相距25mm左右,與培養(yǎng)皿邊緣相距15mm以上。每個培養(yǎng)皿為一種防腐劑的4個濃度。用微量移液器吸取防腐劑6ul到孔內(nèi),讓防腐劑剛好齊培養(yǎng)基面,蓋好培養(yǎng)皿。
7、培養(yǎng)并觀察抑菌效果
于37℃生化培養(yǎng)箱中正置培養(yǎng),培養(yǎng)16-18小時觀察結果。測量抑菌圈并記錄。
四、實驗結果
1、紙片法實驗數(shù)據(jù)和圖片
16h | 防腐劑1 | 防腐劑2 | 防腐劑3 | 防腐劑4 | P**300 |
1/250 | 2.2 | 2.0 | 1.9 | 2.1 | 1.4 |
1/500 | 1.7 | 1.7 | 1.5 | 1.7 | 1.1 |
1/1000 | 1.5 | 1.5 | 1.2 | 1.4 | 0.6 |
1/2000 | 0.6 | 0.8 | 0.9 | 1.2 | 0.5 |

2、打孔法實驗數(shù)據(jù)和圖片
打孔法(1/10)
16h | 防腐劑1 | 防腐劑2 | 防腐劑3 | 防腐劑4 | P**300 |
1/250 | 2.2 | 2.2 | 2.0 | 2.2 | 1.5 |
1/500 | 1.9 | 1.8 | 1.6 | 1.9 | 1.1 |
1/1000 | 1.5 | 1.5 | 1.4 | 1.5 | 0.9 |
1/2000 | 1.1 | 1.0 | 1.0 | 1.2 | 0.6 |

打孔法(1/2)
16h | 防腐劑1 | 防腐劑2 | 防腐劑3 | 防腐劑4 | P**300 |
1/250 | 2.2 | 2.0 | 1.9 | 2.1 | 1.5 |
1/500 | 1.8 | 1.7 | 1.6 | 1.7 | 1.2 |
1/1000 | 1.5 | 1.4 | 1.3 | 1.5 | 0.9 |
1/2000 | 1.1 | 1.0 | 1.1 | 1.1 | 0.5 |

結論
從兩次實驗結果來看,防腐劑P1-P4的抑菌效果都是優(yōu)于對照P**300的抑菌效果。
從抑菌濃度來看,防腐劑P1-P4的1/1000的效果跟對照P**300的1/250的效果相當。
總結
總體來看,西寶的公司KV300之P1-P4批次的抑菌效果明顯優(yōu)于P**300,1:1000~1:2000高稀釋倍數(shù)的抑菌效果差距明顯。故建議具體使用濃度視溶液營養(yǎng)份而定,但不宜稀釋過低。實驗顯示西寶KroVin300在細菌、霉菌、酵母菌的殺菌抑菌效果上明顯優(yōu)于某進口品牌的P**300。
相關文章
免費索樣或咨詢KroVin防腐劑信息,請致電 400-021-8158聯(lián)系西寶生物。
KroVin系列防腐劑產(chǎn)品列表
| 物料編碼 | 產(chǎn)品名稱 | 包裝規(guī)格 |
| ACN0054A | KroVin 100 | 100ml,500ml,1L |
| ACN0037B | KroVin 300 | 25ml,100ml,500ml,1L,5L |
| ACN0046A | KroVin 500 | 25ml,100ml,500ml,1L |
| ACN0043B | KroVin 950 | 25ml,100ml,500ml,1L,5L |
| ACN0911A | KroVin 1100 | 25ml,500ml,5L |
如果以上防腐劑都未能滿足您的要求,可將您的樣本體系寄給我司,我們將為您定制開發(fā)。
一、實驗原理
利用抑菌劑不斷溶解經(jīng)瓊脂擴散形成不同濃度梯度,已顯示其抑菌作用。實驗通過抑菌圈大小判斷其是否具有抑菌能力。
二、實驗器材
100mm培養(yǎng)皿、離心管、移液器、超凈臺、計數(shù)板、生理鹽水、生化培養(yǎng)箱、無菌蒸餾水、接種環(huán)、大豆酪蛋白瓊脂培養(yǎng)基等。
菌種:
自然菌液: 吸取西寶生物實驗室水槽,衛(wèi)生間下水池,一樓下水管,以及大門口的養(yǎng)魚池的水,一共大約20ml, 進行自然沉降,取上清液部分。
防腐劑:
1.Seebio KroVin300防腐劑(共四個批次,用P1、P2、P3、P4標識)
2.某進口品牌的P**300
2.某進口品牌的P**300
三、實驗步驟
1、實驗工具準備及滅菌
2、培養(yǎng)基制備
稱取10.5g培養(yǎng)基干粉,加入300ml純化水,攪拌加熱煮沸至完全溶解。再加入6g的葡萄糖,攪拌溶解。向各培養(yǎng)皿內(nèi)注入約20ml的熔化狀瓊脂培養(yǎng)基(約45℃),待其冷卻,備用。
3、防腐劑配制
用蒸餾水對不同類防腐劑分別按照1:250、1:500、1:1000、1:2000配制 ,做好標記。
4、菌懸液制備
取適量菌種加入生理鹽水1ml,稀釋10倍,采用平板計數(shù)法,稀釋,得到10^6CFU/ml濃度菌懸液。
5、試驗菌接種
10^6CFU/ml試驗菌懸液0.2ml,將其接種到已經(jīng)倒好培養(yǎng)基的培養(yǎng)皿內(nèi),用涂布棒涂布均勻(每次使用涂布棒前酒精燈下滅菌),蓋好培養(yǎng)皿。
6、添加防腐劑
6.1 紙片法
用鑷子將圓片約5.5mm濾紙平均放置在培養(yǎng)皿上,每個培養(yǎng)皿放置4個圓濾紙(4個防腐劑濃度用)。吸取不同種類,不同濃度的防腐劑3ul,加入到圓濾紙中,讓防腐劑溶液分布滿整個濾紙,但又不溢出,蓋好培養(yǎng)皿。
6.2 打孔法
在培養(yǎng)皿里培養(yǎng)基上打4個孔,用100ul槍頭打孔。各孔中心之間相距25mm左右,與培養(yǎng)皿邊緣相距15mm以上。每個培養(yǎng)皿為一種防腐劑的4個濃度。用微量移液器吸取防腐劑6ul到孔內(nèi),讓防腐劑剛好齊培養(yǎng)基面,蓋好培養(yǎng)皿。
7、培養(yǎng)并觀察抑菌效果
于37℃生化培養(yǎng)箱中正置培養(yǎng),培養(yǎng)16-18小時觀察結果。測量抑菌圈并記錄。
四、實驗結果
1、紙片法實驗數(shù)據(jù)和圖片
16h | 防腐劑1 | 防腐劑2 | 防腐劑3 | 防腐劑4 | P**300 |
1/250 | 2.2 | 2.0 | 1.9 | 2.1 | 1.4 |
1/500 | 1.7 | 1.7 | 1.5 | 1.7 | 1.1 |
1/1000 | 1.5 | 1.5 | 1.2 | 1.4 | 0.6 |
1/2000 | 0.6 | 0.8 | 0.9 | 1.2 | 0.5 |
2、打孔法實驗數(shù)據(jù)和圖片
打孔法(1/10)
16h | 防腐劑1 | 防腐劑2 | 防腐劑3 | 防腐劑4 | P**300 |
1/250 | 2.2 | 2.2 | 2.0 | 2.2 | 1.5 |
1/500 | 1.9 | 1.8 | 1.6 | 1.9 | 1.1 |
1/1000 | 1.5 | 1.5 | 1.4 | 1.5 | 0.9 |
1/2000 | 1.1 | 1.0 | 1.0 | 1.2 | 0.6 |

打孔法(1/2)
16h | 防腐劑1 | 防腐劑2 | 防腐劑3 | 防腐劑4 | P**300 |
1/250 | 2.2 | 2.0 | 1.9 | 2.1 | 1.5 |
1/500 | 1.8 | 1.7 | 1.6 | 1.7 | 1.2 |
1/1000 | 1.5 | 1.4 | 1.3 | 1.5 | 0.9 |
1/2000 | 1.1 | 1.0 | 1.1 | 1.1 | 0.5 |

結論
從兩次實驗結果來看,防腐劑P1-P4的抑菌效果都是優(yōu)于對照P**300的抑菌效果。
從抑菌濃度來看,防腐劑P1-P4的1/1000的效果跟對照P**300的1/250的效果相當。
總結
總體來看,西寶的公司KV300之P1-P4批次的抑菌效果明顯優(yōu)于P**300,1:1000~1:2000高稀釋倍數(shù)的抑菌效果差距明顯。故建議具體使用濃度視溶液營養(yǎng)份而定,但不宜稀釋過低。實驗顯示西寶KroVin300在細菌、霉菌、酵母菌的殺菌抑菌效果上明顯優(yōu)于某進口品牌的P**300。
相關文章
免費索樣或咨詢KroVin防腐劑信息,請致電 400-021-8158聯(lián)系西寶生物。
KroVin系列防腐劑產(chǎn)品列表
| 物料編碼 | 產(chǎn)品名稱 | 包裝規(guī)格 |
| ACN0054A | KroVin 100 | 100ml,500ml,1L |
| ACN0037B | KroVin 300 | 25ml,100ml,500ml,1L,5L |
| ACN0046A | KroVin 500 | 25ml,100ml,500ml,1L |
| ACN0043B | KroVin 950 | 25ml,100ml,500ml,1L,5L |
| ACN0911A | KroVin 1100 | 25ml,500ml,5L |
如果以上防腐劑都未能滿足您的要求,可將您的樣本體系寄給我司,我們將為您定制開發(fā)。



